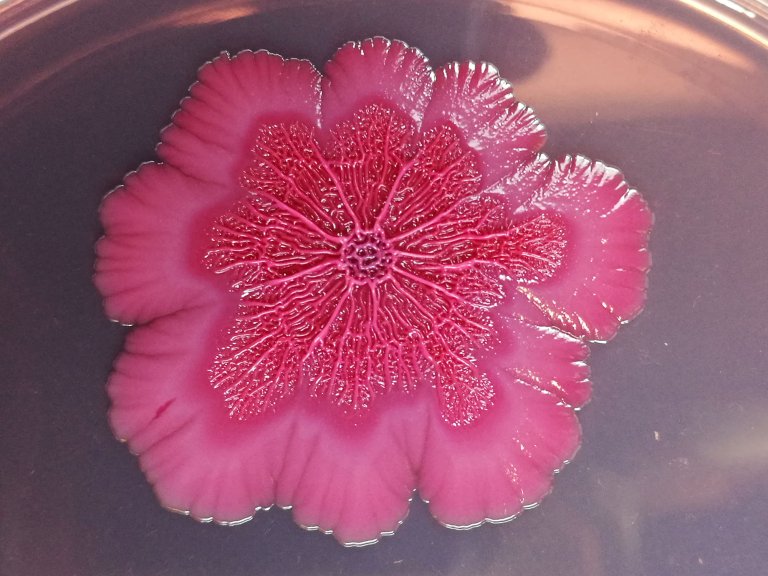
biofilm - foto Anna Eline Bruvoll

Biofilm
Our research within this area is focused on the role of biofilms for development, persistence and spread of antimicrobial resistant bacteria, as well as antimicrobial resistance genes. We study evolution and dissemination of resistance within the biofilm, both through selection of resistant bacteria and transfer of resistance genes. Furthermore, we investigate the biofilm forming properties of the bacteria and the effect of matrix components of under different conditions and on various surfaces. Comparison of the biofilm forming properties of persistent and non-persistent bacteria from food production elucidates the role of biofilm in persistence in production environments. As the biofilm lifestyle may offer protection against eradication by disinfection, we test the effect of different disinfectants on antimicrobial resistant bacteria in biofilm. We also look at strategies to prevent biofilm formation, including various biofilm inhibiting compounds.